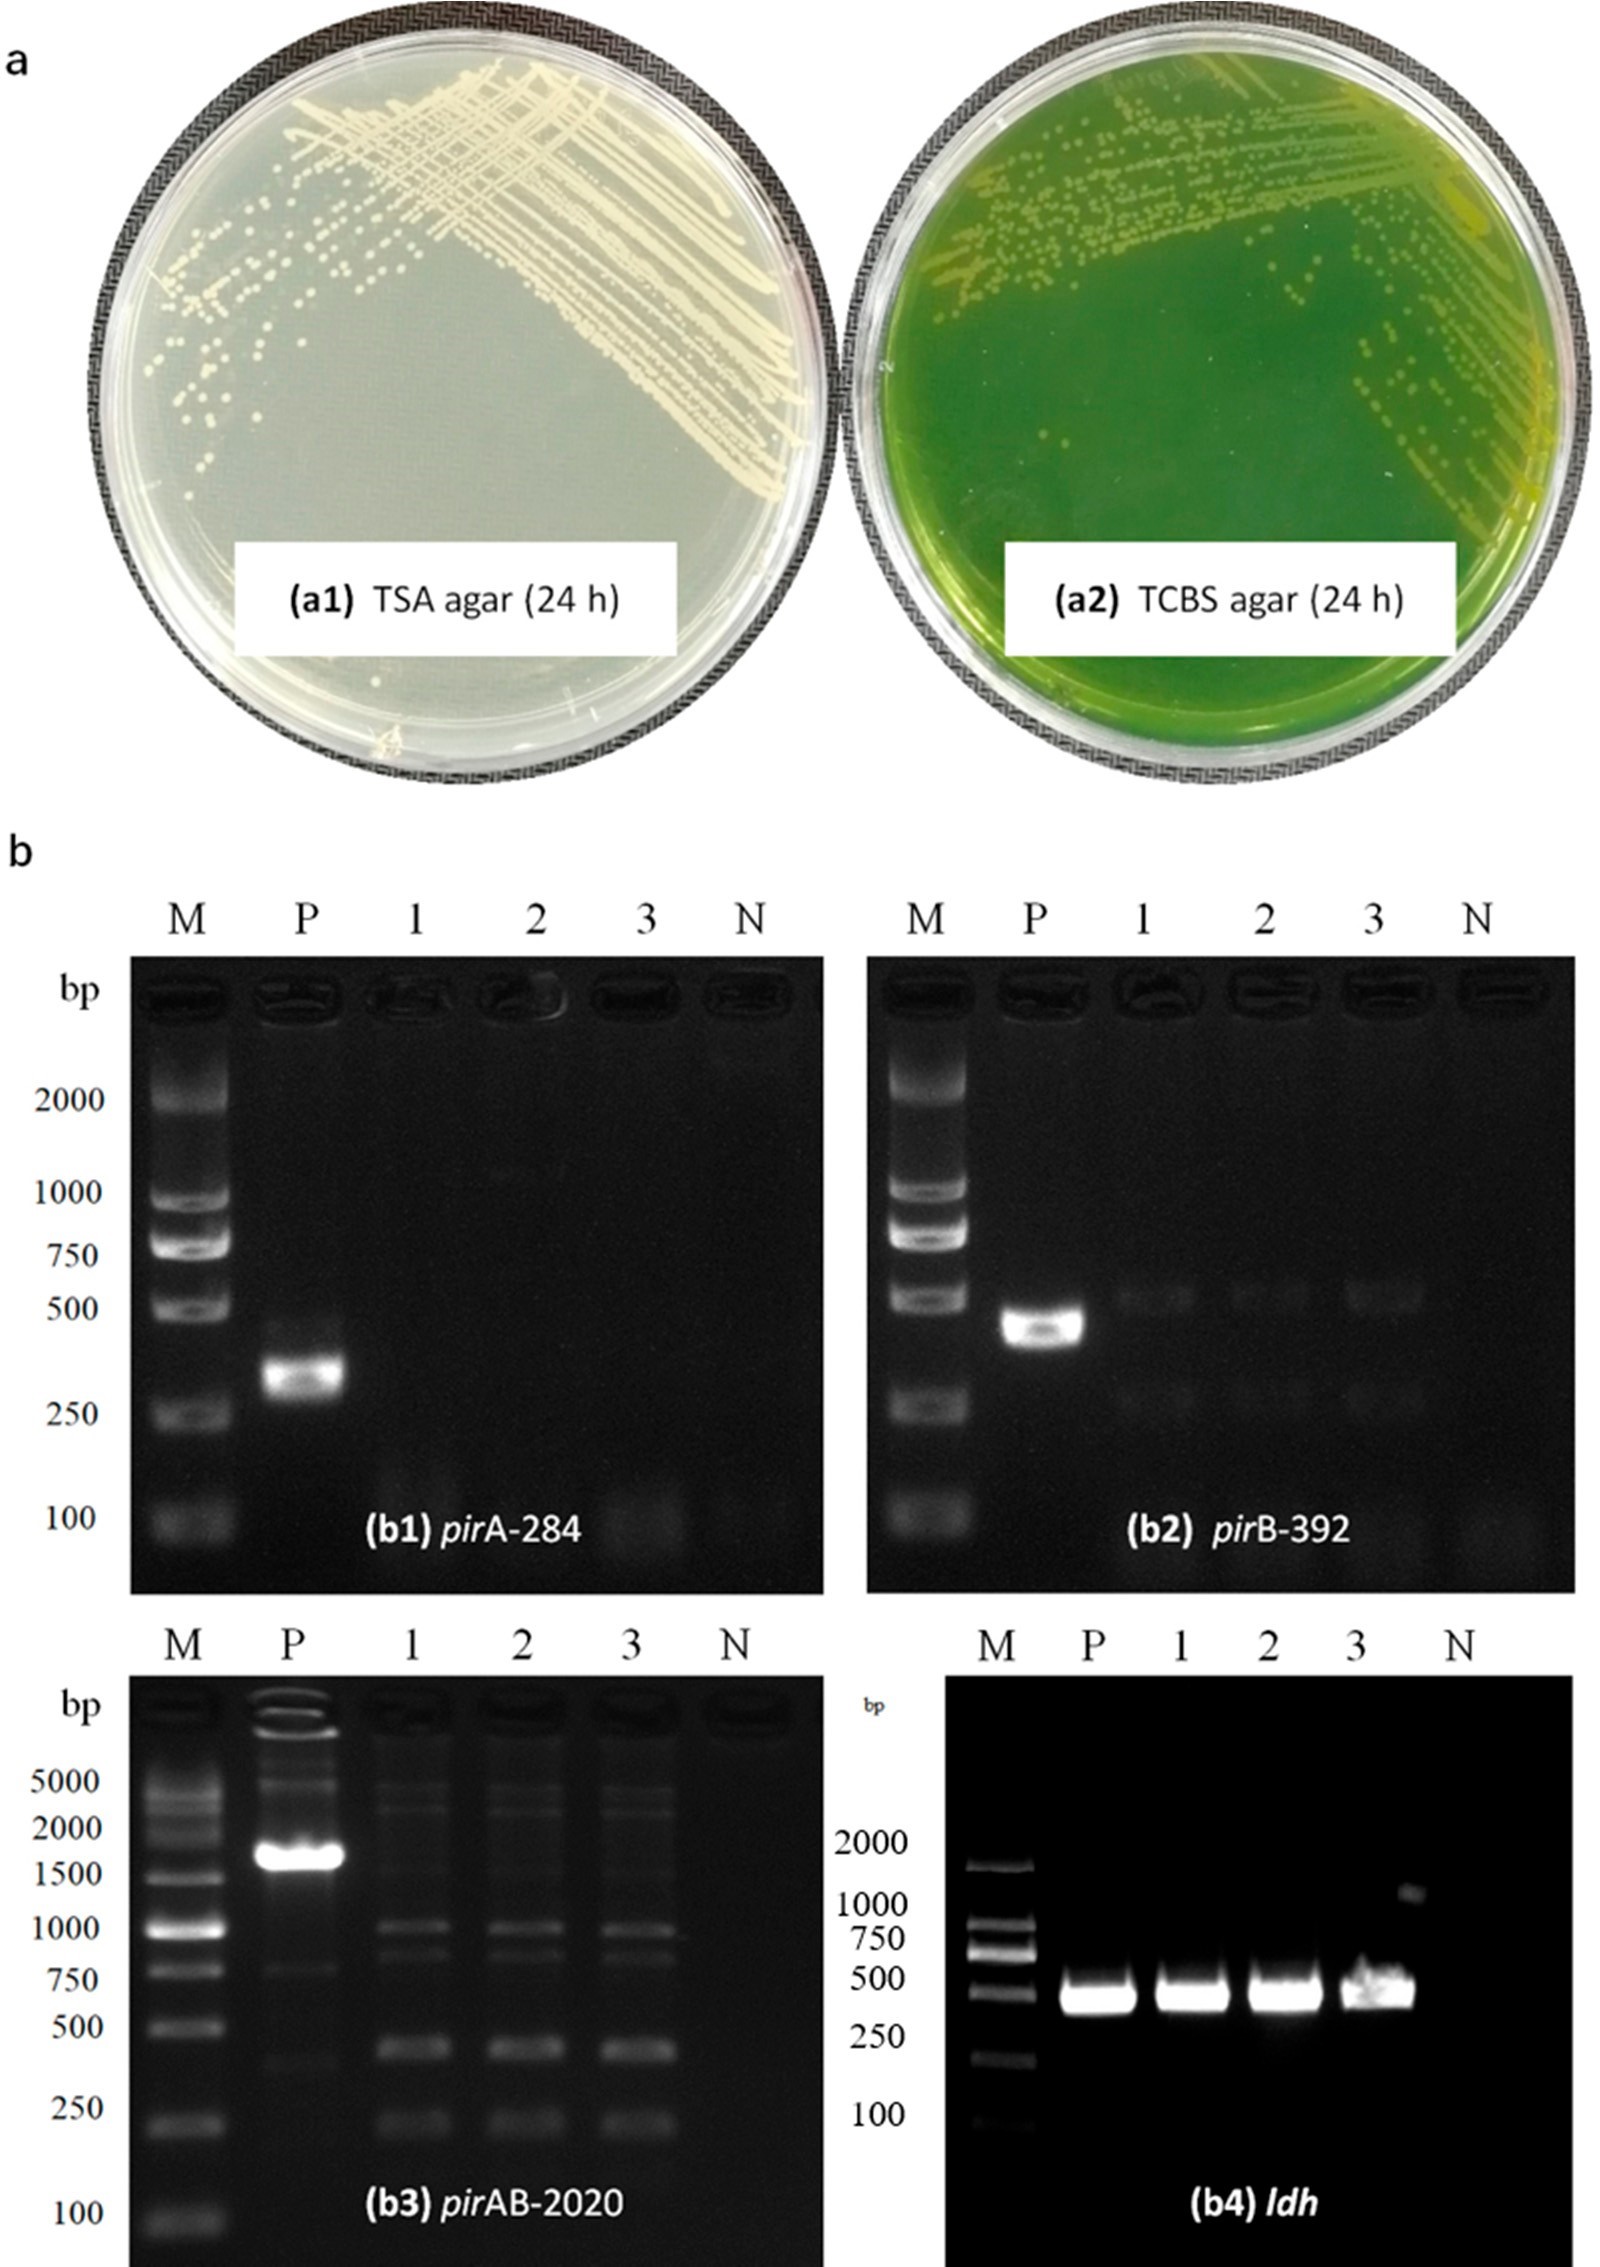

Một mầm bệnh mới có tên là “bệnh mờ đục trên hậu ấu trùng” (translucent post-larvae disease – TPD) hay “bệnh thân thủy tinh trên hậu ấu trùng” (glass post-larvae disease – GPD) tôm thẻ chân trắng Penaeus vannamei, có đặc điểm là gan tụy và đường tiêu hóa nhợt nhạt hoặc không màu, đã trở thành mối đe dọa cấp bách đối với ngành nuôi tôm. Có ý kiến cho rằng việc điều trị bằng chất kháng khuẩn có thể làm giảm bớt phần nào dịch bệnh này, vì vậy một cuộc điều tra có hệ thống về tác nhân lây nhiễm TPD tiềm ẩn đã được thực hiện, bằng cách sử dụng phương pháp xác định vi khuẩn và thử nghiệm cảm nhiễm tuân theo các nguyên tắc của Koch. Một chủng vi khuẩn chiếm ưu thế, Vp-JS20200428004-2, từ các cá thể tôm trong tình trạng “gần chết” đã được phân lập và xác định là Vibrio parahaemolyticus dựa trên phương pháp phân tích trình tự đa điểm. Tuy nhiên, Vp-JS20200428004-2 khác với V. parahaemolyticus gây bệnh hoại tử gan tụy cấp tính. Các thử nghiệm cảm nhiễm bằng cách ngâm cho thấy Vp-JS20200428004-2 có thể gây chết 100% trong vòng 40 giờ với liều 1,83×106 CFU/mL và tôm nhiễm bệnh có dấu hiệu lâm sàng tương tự như TPD. Vp-JS20200428004-2 có thể được phân lập lại và xác định từ các cá thể bị nhiễm bệnh trong thử nghiệm. Hơn nữa, phân tích mô bệnh học của các mẫu bệnh chỉ ra rằng Vp-JS20200428004-2 gây hoại tử và bong tróc nghiêm trọng các tế bào biểu mô của gan tụy và ruột giữa ở các cá thể tôm bị nhiễm bệnh tự nhiên và nhiễm bệnh trong thử nghiệm cảm nhiễm. Kết quả hiện tại của chúng tôi chỉ ra rằng Vp-JS20200428004-2 là một tác nhân truyền nhiễm có độc lực cao liên quan đến TPD và cần được quan tâm nhiều hơn.
1. Giới thiệu
Nuôi trồng thủy sản, bao gồm cả nuôi tôm, là ngành sản xuất thực phẩm có nguồn gốc từ động vật phát triển nhanh nhất trên thế giới. Một số bệnh mới, bao gồm bệnh hoại tử gan tụy cấp tính (AHPND), bệnh tôm chết ẩn do Nodavirus (VCMD), nhiễm Enterocytozoon hepatopenaei (EHP) và nhiễm virus gây ánh kim hồng cầu ở tôm (SHIV), đã ảnh hưởng đến ngành nuôi tôm toàn cầu. Gần đây hơn, một mầm bệnh mới có tên là “bệnh mờ đục trên hậu ấu trùng” (TPD) hay “bệnh thân thủy tinh trên hậu ấu trùng” (GPD) tôm thẻ chân trắng Penaeus vannamei đã trở thành mối đe dọa ngày càng tăng đối với nghề nuôi tôm ở Trung Quốc.
Kể từ tháng 3 năm 2020, một số lượng lớn các trường hợp bệnh TPD đã xảy ra ở một số trại sản xuất giống P. vannamei ở các tỉnh Quảng Đông và Quảng Tây, sau đó mầm bệnh mới này bắt đầu lan sang các vùng nuôi tôm lớn ở phía bắc Trung Quốc thông qua vận chuyển tôm giống (PL) vào tháng 4 năm 2020. Bệnh mờ đục hậu ấu trùng chủ yếu ảnh hưởng ở hậu ấu trùng từ 4-7 ngày tuổi (PL4~PL7) với mức độ lây nhiễm rất nặng. Thông thường, tỷ lệ mắc bệnh của quần thể bị bệnh có thể lên tới 60% vào ngày thứ hai sau lần đầu tiên quan sát thấy những cá thể bất thường, và thậm chí lên tới 90–100% trong những trường hợp nặng vào ngày thứ ba. Tôm nhiễm bệnh mờ đục trên hậu ấu trùng chủ yếu có các dấu hiệu lâm sàng tổng thể như gan tụy nhợt nhạt hoặc không màu, đường tiêu hóa rỗng, khiến cơ thể tôm bị bệnh trở nên trong suốt và mờ; do đó, những con tôm bị bệnh này được nông dân địa phương đặt tên là “bệnh mờ đục trên hậu ấu trùng” hoặc “bệnh thân thủy tinh trên hậu ấu trùng”.
Do bệnh TPD đã trở nên phổ biến ở tôm nuôi, gây thiệt hại kinh tế nghiêm trọng ở một số vùng nuôi tôm ở Trung Quốc, nên việc điều tra và phát triển các chiến lược ngăn ngừa dịch bệnh này là một điều cực kỳ cần thiết. Chúng tôi đã lấy mẫu tôm TPD và sàng lọc các mầm bệnh đã biết, nhưng xét nghiệm PCR chỉ ra rằng tôm TPD không có mầm bệnh tôm đã biết, bao gồm virus gây hội chứng đốm trắng (WSSV), virus gây hoại tử cơ quan tạo máu và cơ quan lập biểu mô (IHHNV), VAHPND, SHIV, virus gây bệnh đầu vàng (YHV), virus gây hội chứng Taura (TSV) và virus gây hoại tử cơ (IMNV). Những kết quả này cho thấy TPD có thể do một mầm bệnh mới gây ra. Ngoài ra, một số nông dân nhận thấy rằng việc xử lý nước trong bể nuôi bằng chất kháng khuẩn có thể làm giảm bệnh. Điều này cho thấy mầm bệnh này có thể do mầm bệnh vi khuẩn gây ra. Do đó, một cuộc điều tra có hệ thống về tác nhân lây nhiễm TPD tiềm ẩn đã được thực hiện dựa trên việc phân lập và xác định vi khuẩn, thử nghiệm cảm nhiễm và phân tích mô bệnh học, kết quả được trình bày trong nghiên cứu này.
2. Kết quả
2.1. Dấu hiệu lâm sàng
Các dấu hiệu lâm sàng của tôm bị bệnh, từ các thử nghiệm cảm nhiễm hoặc các bể nuôi bị nhiễm TPD tự nhiên, đều tương tự nhau, với gan tụy và đường tiêu hóa bất thường như được thể hiện trong Hình 1. Gan tụy và đường tiêu hóa của hậu ấu trùng tôm bị bệnh trở nên nhợt nhạt và không màu (Hình 1a). Một tỷ lệ lớn hậu ấu trùng bị ảnh hưởng chìm xuống đáy bể do khả năng bơi lội giảm.

Hình 1: Dấu hiệu lâm sàng của tôm thẻ chân trắng bị ảnh hưởng bởi bệnh mờ đục trên hậu ấu trùng (TPD). (a) Tôm P. vannamei được thu thập từ các bể nuôi hậu ấu trùng bị ảnh hưởng bởi TPD. (b) Tôm P. vannamei được thu thập từ thử nghiệm cảm nhiễm. Tất cả các mẫu đều ở giai đoạn PL7 và chiều dài cơ thể khoảng 0,6–0,9 cm. Những cá thể mắc bệnh (được biểu thị bằng mũi tên trắng) có biểu hiện gan tụy và hoại tử đường tiêu hóa bất thường. Gan tụy và đường tiêu hóa của hậu ấu trùng bị bệnh nhợt nhạt, không màu.
2.2. Phát hiện mầm bệnh đã biết trong các mẫu bệnh
Kết quả phát hiện cho thấy 8 mầm bệnh tôm đã biết, bao gồm VAHPND, WSSV, IHHNV, EHP, SHIV, YHV, TSV và IMNV, đều âm tính trong các mẫu tôm bị TPD. Những kết quả này cho thấy tôm TPD có thể bị ảnh hưởng bởi một mầm bệnh mới.
2.3. Xác định vi khuẩn
Trình tự của các sản phẩm PCR đã được xử lý bằng phần mềm BLAST. Phân tích trình tự gen 16S rRNA cho thấy cả 10 chủng trội, trong đó có JS20200428004-2 thuộc giống Vibrios có độ tương đồng cao nhất với V. parahaemolyticus (99,93%). Việc xác định sâu hơn về phân loại vi khuẩn được thực hiện bằng phân tích trình tự đa điểm (MLSA). Trình tự MLSA phân tích gen rpoD–rctB–toxR cũng xác định rõ ràng chủng JS20200428004-2 là chủng gần nhất với V. parahaemolyticus (Hình 2). Chủng JS20200428004-2 cho thấy màu trắng sữa trên môi trường thạch TSA với cạnh gọn gàng và bề mặt nổi lên, đường kính là 1,79 mm sau khi ủ trong 24 giờ ở 28°C; tuy nhiên, khuẩn lạc có màu vàng nhạt trên môi trường thạch TCBS và đường kính là 2,04 mm sau khi ủ trong 24 giờ ở 28°C (Hình 3a). Kết quả xác định vi khuẩn cho thấy hậu ấu trùng tôm thẻ P. vannamei có thể là vật mang mầm bệnh hoặc bị nhiễm Vp-JS20200428004-2. Trong khi đó, khuẩn lạc chiếm ưu thế được phân lập từ hậu ấu trùng ở trạng thái gần chết trong thử nghiệm cảm nhiễm được xác định là hoàn toàn phù hợp với Vp-JS20200428004-2 dựa trên phân tích gen 16S rRNA và toxR, xác định rằng vi khuẩn hoạt động trong thử nghiệm cảm nhiễm là chủng Vp-JS20200428004-2. Kết quả xét nghiệm sinh hóa cho thấy các thông số của Vp-JS20200428004-2 giống hệt với thông số của Vibrio.

Hình 2: Tái cấu trúc phát sinh loài dựa trên các chuỗi rpoD, rctB và toxR nối liền của chủng JS20200428004-2. Phần trăm giá trị bootstrap (1000 lần lặp lại). Thanh tỷ lệ = 0,05. Trình tự tham chiếu được mô tả bởi Pascual và cộng sự (2010)
Hình 3: Xác định vi khuẩn và phân tích các gen độc lực. (a) Màu sắc của Vp-JS20200428004-2 nuôi cấy trên thạch TSA và thạch TCBS. (b) Điện di phát hiện phân tử gen độc tố pirA (b1), pirB (b2), pirAB2020VP (b3) và ldh (b4) của các chủng thu thập được trong nghiên cứu này. p: đối chứng dương; N: đối chứng âm; 1-3: JS20200428004-2. M: Điểm đánh dấu phân tử.
2.4. Các gen độc lực ở chủng cô lập
Bộ khuếch đại PCR 450 bp của gen ldh từ Vp-JS20200428004-2 (Hình 3(b4)) đã được giải trình tự và gửi đến trang web NCBI để phân tích BLAST. Kết quả cho thấy chủng Vp-JS20200428004-2 mang gen ldh (còn gọi là gen hemolysin không bền nhiệt, tlh) và có sự tương đồng 100% với các gen tlh đã biết của V. parahaemolyticus. Sau đó, các bộ mồi pirA-284F/R và pirB-392F/R đã tạo ra các bộ khuếch đại của mục tiêu bằng cách sử dụng DNA của chủng VAHPND tiêu chuẩn phân lập làm mẫu, trong khi không thể khuếch đại DNA của chủng Vp-JS20200428004-2 (Hình 3(b1, b2)). Ngoài ra, toàn bộ gen độc tố PirABVp cùng với một phần của vùng trước và sau gen của chúng có chiều dài là 2020 bp được thu thập từ phân lập VAHPND tiêu chuẩn bằng cách sử dụng mồi pirAB2020-F/R; tuy nhiên, các đoạn mồi tương tự không thể tạo ra bộ khuếch đại PCR khi sử dụng DNA của Vp-JS20200428004-2 làm mẫu (Hình 3(b3)). Kết quả xét nghiệm gen độc tố PirABVp chỉ ra rằng chủng Vp-JS20200428004-2 phân lập thiếu gen pirAVp và pirBVp.
2.5. Khả năng gây bệnh của Vibrio Parahaemolyticus được xác định bằng thử nghiệm cảm nhiễm
Tỷ lệ chết của hậu ấu trùng tôm P. vannamei cảm nhiễm TPD ở nồng độ 1,83×107 CFU/mL được xác định là cao nhất trong số tất cả các nhóm bị nhiễm bệnh và tỷ lệ chết 100% được quan sát thấy trong 28 giờ sau cảm nhiễm. Tỷ lệ chết 100% ở nhóm 1,83×106 CFU/mL xảy ra sau 40 giờ sau cảm nhiễm. Cuối cùng, tỷ lệ chết 75% ở nhóm 1,83×104 CFU/mL (nồng độ vi khuẩn thấp nhất được sử dụng trong các thử nghiệm cảm nhiễm trong nghiên cứu này) xảy ra trong 48 giờ sau cảm nhiễm. Ngược lại, không có tỷ lệ chết ở nhóm đối chứng âm trong thời gian thử nghiệm (Hình 4). Trong thử nghiệm cảm nhiễm, nồng độ gây chết 50% (LC50) sau 24 giờ là 9,84×105 CFU/mL và thời gian gây chết 50% (LT50) trong các thử nghiệm cảm nhiễm 56 giờ với liều 1,83×107, 1,83×106, 1,83×105 và 1,83×104 CFU/mL lần lượt là 15,7 giờ; 24,6 giờ; 28,9 giờ và 38,6 giờ.

Hình 4: Tỷ lệ chết tích lũy của tôm thẻ chân trắng Penaeus vannamei do ngâm vi khuẩn trong gradient nồng độ Vp-JS20200428004-2. Bốn nhóm tôm khỏe mạnh được ngâm trong nồng độ vi khuẩn pha loãng đến 1,83×107 ~ 1,83×104 CFU/mL (nhóm cảm nhiễm) và một nhóm được ngâm trong nước biển (nhóm đối chứng). Tỷ lệ chết tích lũy của tôm được thể hiện dưới dạng giá trị trung bình và độ lêch chuẩn (SD) của dữ liệu từ hai lần lặp lại cho mỗi nhóm thử nghiệm.
Trong khi đó, hầu hết các cá thể tôm trong nhóm bị cảm nhiễm đều có các dấu hiệu lâm sàng điển hình của TPD, bao gồm gan tụy và ruột giữa nhợt nhạt, không màu. Đồng thời, tôm bị bệnh có dấu hiệu thiếu thức ăn trong gan tụy và đường tiêu hóa ở độ phóng đại cao (Hình 1b).
2.6. Phân tích mô bệnh học của của tôm nhiễm VibrioKiểm tra mô bệnh học tôm nhiễm bệnh tự nhiên cho thấy hoại tử và sự bong tróc của các tế bào biểu mô xảy ra ở ống gan tụy và ruột giữa (Hình 5). Trong giai đoạn đầu của bệnh, hoại tử tế bào biểu mô ở ống gan tụy với mức độ nhẹ (Hình 5a, b), nhưng hoại tử và bong tróc tế bào biểu mô nghiêm trọng ở ruột giữa (Hình 5e). Hoại tử và bong tróc các tế bào biểu mô trở nên rất nghiêm trọng, và các dấu hiệu điển hình của sự xâm nhập vi khuẩn đáng kể cả trong lòng ống gan tụy và lòng ruột giữa có thể được quan sát thấy trong giai đoạn cấp tính và giai đoạn nhiễm bệnh nặng (Hình 5c, d, f). Sự xâm nhập của vi khuẩn trong gan tụy đã được xác minh bằng cách sử dụng phân tích kính hiển vi điện tử truyền qua (Hình 6a, b). Tất cả các quan sát gần như giống hệt nhau ở gan tụy và đường tiêu hóa của những con tôm nhiễm bệnh được lấy mẫu từ các vùng khác nhau.

Hình 5: Phần mô học của hậu ấu trùng nhiễm TPD tự nhiên. (a, b) Giai đoạn đầu với sự phá hủy gan tụy. Lưu ý sự hoại tử nhẹ của các tế bào biểu mô (EC) ống gan tụy (HP), đặc biệt là các EC trong các ô chấm cho thấy các hạt nhân sẫm màu, nhỏ hơn và đặc trưng. Sự xâm nhập của vi khuẩn (BC) trong giai đoạn đầu của quá trình nhiễm bệnh được biểu thị bằng mũi tên đen. Các EC có mũi tên (mũi tên đen) là các tế bào B có không bào lớn. (c, d) Giai đoạn cấp tính với sự xâm nhập mạnh mẽ của vi khuẩn. Có sự xâm nhập đáng kể của vi khuẩn vào các ống gan tụy ở một nửa số cơ quan, nơi các khối vi khuẩn và các ống thận bị phá hủy. Lưu ý sự bong tróc EC ống gan tụy (mũi tên trắng). (e, f) Ruột giữa của đường tiêu hóa ở hậu ấu trùng bị nhiễm bệnh tự nhiên có biểu hiện hoại tử (hộp chấm) và bong tróc (mũi tên trắng) EC của đường tiêu hóa. Lưu ý số lượng BC trong lòng ống của đường tiêu hóa ở ruột giữa. (b), (b1), (d) và (e) lần lượt là các ảnh vi mô phóng to của khu vực trong khung đen ở (a – c) và (e0). (a, b, e) cho thấy sự thay đổi bệnh lý trong giai đoạn đầu của nhiễm bệnh. (c, d, f) cho thấy sự thay đổi bệnh lý trong giai đoạn cấp tính. Thanh tỷ lệ = (a) 100 μm, (b) 20 μm, (c) 100 μm, (d) 20 μm, (e0) 100 μm, (e) 10 μm và (f) 5 μm.

Hình 6: Sự xâm nhập của vi khuẩn vào HP của hậu ấu trùng nhiễm TPD tự nhiên dưới kính hiển vi điện tử truyền qua. (b) Ảnh vi mô phóng đại của vùng trong khung đen ở (a).
Mô bệnh học của tôm trong thử nghiệm cảm nhiễm với V. parahaemolyticus (Vp-JS20200428004-2) chỉ ra rằng các tế bào biểu mô ống HP cho thấy hoại tử và bong tróc vào trong lòng ống HP (Hình 7a–d). Ở giai đoạn đầu, sự hoại tử và bong tróc của tế bào biểu mô cũng xuất hiện ở đường tiêu hóa của đoạn ruột giữa (Hình 8a). Khi nhiễm trùng trở nên nghiêm trọng hơn, hoại tử và bong tróc nghiêm trọng các tế bào biểu mô được quan sát thấy ở cả ống gan tụy (Hình 7c, d) và đường tiêu hóa ở ruột giữa (Hình 8b) ở giai đoạn giữa của nhiễm bệnh. Sự tạo hắc tố do nhiễm vi khuẩn thể hiện rõ ràng ở các tế bào biểu mô gan tụy (Hình 7d), và triệu chứng tương tự của sự hắc tố hóa cũng xuất hiện ở các tế bào biểu mô gan tụy của tôm bị nhiễm bệnh tự nhiên. Các dấu hiệu rõ ràng về sự xâm nhập của vi khuẩn cũng xảy ra ở cả lòng ống HP (Hình 7f) và đường tiêu hóa (Hình 8c) trong giai đoạn nhiễm bệnh nặng.

Hình 7: Các phần mô học của hậu ấu trùng bị cảm nhiễm bằng cách ngâm cho thấy các tổn thương TPD tương tự ở gan tụy (HP) do phân lập Vp-JS20200428004-2 gây ra. (a, b) Giai đoạn đầu với sự phá hủy HP. Các ống HP bị ảnh hưởng cho thấy sự hoại tử rõ ràng của các tế bào biểu mô (EC) (hộp chấm) với nhân sẫm màu, nhỏ hơn và đặc trưng. (c, d) Giai đoạn giữa với sự hình thành hắc tố rõ ràng (mũi tên đen) và sự xâm chiếm của vi khuẩn (BC) trong HP. (e, f) Giai đoạn cấp tính với sự xâm nhập lớn của vi khuẩn. Một số lượng lớn vi khuẩn chiếm giữ các ống gan tụy. Lưu ý sự bong tróc của EC gan tụy (mũi tên trắng). (b, d, f) lần lượt là các ảnh vi mô phóng to của vùng trong khung đen trong (a, c, e). Sự bong tróc của EC trong ống HP được biểu thị bằng các mũi tên màu trắng. Lưu ý BC trong các tế bào biểu mô trong lòng ống HP. Thanh tỷ lệ = (a) 100 μm, (b) 20 μm, (c) 250 μm, (d) 20 μm, (e) 100 μm và (f) 20 μm.

Hình 8: Các phần mô học của đường tiêu hóa ở hậu ấu trùng bị cảm nhiễm. (a) Giai đoạn đầu của đường tiêu hóa bị ảnh hưởng ở ruột giữa cho thấy hoại tử (hộp chấm) và bong tróc các tế bào biểu mô (EC) của đường tiêu hóa (mũi tên trắng). (b) Giai đoạn giữa với sự hoại tử nghiêm trọng EC của đường tiêu hóa. (c) Giai đoạn bệnh nặng với BC. (b) là ảnh vi mô phóng đại của vùng trong khung màu đen ở (b0). Thanh tỷ lệ = (a) 20 m, (b0) 100 m, (b) 10 m và (c) 5 m.
3. Thảo luận
Trong thập kỷ qua, ngành nuôi tôm thế giới đã bị ảnh hưởng nặng nề bởi một số mầm bệnh mới và sự tái nhiễm của một số mầm bệnh đã biết. Một trong những bệnh chính đó là AHPND, còn được gọi là hội chứng chết sớm (EMS). AHPND đã lan sang các nước nuôi tôm khác kể từ khi nó được báo cáo lần đầu tiên ở Việt Nam và Trung Quốc vào năm 2010. Sự phổ biến của AHPND trên toàn cầu đã gây thiệt hại đáng kể trong sản xuất tôm ở Thái Lan, Việt Nam, Trung Quốc, Malaysia và Mexico, và thiệt hại kinh tế toàn cầu trực tiếp do AHPND gây ra là hơn 44 tỷ USD từ năm 2010-2016.
Tác nhân gây bệnh AHPND được chứng minh là do một số chủng Vibrio (VAHPND) đặc biệt mang plasmid khoảng 70 kb mang gen tạo độc tố giống với độc tố kép (Pir) PirA và PirB liên quan đến vi khuẩn Photorhabdus. Các tổn thương đặc trưng của AHPND được đặc trưng bởi sự bong tróc lớn các tế bào biểu mô ống của gan tụy tôm (HP). Ngay từ đầu, VAHPND được cho là tác nhân gây bệnh TPD vì các dấu hiệu lâm sàng tổng thể của hậu ấu trùng bị nhiễm bệnh tương tự như hội chứng AHPND ở một mức độ nào đó. Tuy nhiên, cả phương pháp PCR lồng AP4 và xét nghiệm duplex PCR pirABVp của các mẫu tôm nhiễm TPD đều cho kết quả âm tính đối với xét nghiệm VAHPND. Ngoài ra, AHPND xảy ra trong khoảng 35 ngày sau khi thả vào ao nuôi tôm, và sự xuất hiện các dấu hiệu lâm sàng và tỷ lệ chết của AHPND bắt đầu sớm nhất là 10 ngày sau khi thả giống trong một số trường hợp nghiêm trọng. Trong khi đó, TPD thường xảy ra ở giai đoạn hậu ấu trùng từ 4 đến 7 ngày tuổi, sớm hơn nhiều so với thời điểm AHPND xuất hiện. Do đó, chúng tôi suy luận rằng TPD là một căn bệnh mới khác với AHPND.
Kết quả của các xét nghiệm phân tử cho thấy các cá thể bị bệnh trong các bể nuôi hậu ấu trùng bị ảnh hưởng bởi TPD đều âm tính với WSSV, IHHNV, VAHPND, EHP, SHIV, YHV, TSV và IMNV. Để kiểm tra rằng rằng việc sử dụng chất kháng khuẩn trong bể nuôi có thể giúp giảm bệnh hay không, chúng tôi đã tiến hành phân lập và xác định mầm bệnh vi khuẩn từ các mẫu P. vannamei bị nhiễm TPD. Vi khuẩn chiếm ưu thế phân lập từ tôm bị nhiễm bệnh đang trong tình trạng gần chết được xác định là V. parahaemolyticus theo sự sắp xếp trình tự và phân tích cây phát sinh hệ thống dựa trên 16S rDNA và trình tự ba gen độc tố. Phân tích khả năng gây bệnh của V. parahaemolyticus trong thử nghiệm cảm nhiễm chỉ ra rằng các dấu hiệu lâm sàng điển hình tương tự như dấu hiệu lâm sàng của bệnh TPD tại trang trại. Sự khởi phát và tiến triển của bệnh trong thử nghiệm cảm nhiễm cũng như tỷ lệ chết cũng tương tự như TPD ở trang trại. Như vậy, chủng mới V. parahaemolyticus (Vp-JS20200428004-2) được kết luận là tác nhân gây bệnh TPD ở hậu ấu trùng tôm.
Hai loại đột biến xóa đoạn gen pirABVp ở V. parahaemolyticus đã được tìm thấy từ các trang trại bị ảnh hưởng bởi AHPND. Đột biến loại I bao gồm ba chủng bị mất toàn bộ gen pirABVp. Các đột biến loại II bao gồm ba chủng bị mất một phần gen pirAVp và một phần gen pirBVp. Hai loại V. parahaemolyticus này không gây bệnh cho tôm, điều này cho thấy cả pirBVp và pirBVp đều liên quan đến khả năng gây bệnh AHPND. Gần đây, một chủng V. parahaemolyticus phân lập (XN87) thiếu pirBVp nhưng mang pirBVp đã được xác định và nó có thể gây chết 47% mà không gây tổn thương liên quan đến AHPND trong thử nghiệm cảm nhiễm bằng cách ngâm tôm. Phân tích trình tự và độc lực cho thấy XN87 mang plasmid pVA đột biến không tạo ra độc tố PirVp có thể gây chết tôm trong ao. Vào năm 2020, Andrea và cộng sự (2020) báo cáo rằng có một số chủng Vibrio phân lập (phân lập 36 và 43) chứa pirABVp nguyên vẹn, nhưng chúng không tạo ra độc tố pirABVp gây AHPND. Các chủng V. parahaemolyticus không điển hình (phân lập 36 và 43) không tạo ra độc tố pirABVp cũng như bệnh AHPND nhưng vẫn gây chết tôm. Tất cả các báo cáo nêu trên đều cho thấy cơ chế gây bệnh của VAHPND điển hình và V. parahaemolyticus không điển hình phức tạp hơn so với hiểu biết ban đầu của các nhà nghiên cứu. Plasmid pVA không phải lúc nào cũng xác định khả năng gây bệnh của V. parahaemolyticus ở tôm và sự hiện diện của gen độc tố pirABVp là không đủ để xác nhận vi khuẩn gây AHPND. Trong nghiên cứu hiện tại, kết quả phân tích gen độc lực cho thấy phân lập Vp-JS20200428004-2 thiếu gen pirAVp và pirBVp; tuy nhiên, nó sở hữu gen ldh mã hóa yếu tố độc lực quan trọng, hemolysin chịu nhiệt và gây chết tôm. Ngoài ra, Vp-JS20200428004-2 có nồng độ 1,83×106 CFU/mL gây ra tỷ lệ chết 100% trong vòng 40 giờ sau cảm nhiễm; nghĩa là, chủng Vp-JS20200428004-2 dường như có độc lực cao hơn cả VAHPND điển hình và V. parahaemolyticus không điển hình đã được báo cáo trước đây. Những kết quả này cho thấy sự đa dạng cao hơn của V. parahaemolyticus gây bệnh ở tôm.
Hoại tử cấp tính và sự bong tróc các tế bào biểu mô HP xảy ra trong các ống gan tụy từ cả cá thể hậu ấu trùng bị nhiễm tự nhiên và cảm nhiễm. Các dấu hiệu mô bệnh học tổng thể của TPD không giống với AHPND, trong đó có sự bong tróc tế bào lớn của các tế bào biểu mô ống gan tụy. Trong khi đó, các dấu hiệu mô bệnh học của TPD cũng khác với các dấu hiệu do V. parahaemolyticus không điển hình gây ra. Các dấu hiệu mô bệnh học tổng thể đặc biệt của TPD cho thấy cơ chế gây bệnh của Vp-JS20200428004-2 khác với cơ chế gây bệnh của cả VAHPND điển hình và V. parahaemolyticus không điển hình. Để khám phá sâu hơn về cơ chế gây bệnh của Vp-JS20200428004-2, cần thiết kế và tiến hành các nghiên cứu so sánh có hệ thống hơn về Vp-JS20200428004-2, VAHPND điển hình và V. parahaemolyticus không điển hình; thông tin chi tiết về các gen chức năng, plasmid và bộ gen của Vp-JS20200428004-2 cần được nghiên cứu sâu hơn trong tương lai.
Cho đến nay, bệnh Vibriosis do nhiều loài V. spp gây ra đã được báo cáo xảy ra ở các giai đoạn phát triển khác nhau của tôm thẻ P. vannamei bao gồm ấu trùng naup (2 ngày), zoea (4–5 ngày), mysis (3–5 ngày), post (10–15 ngày) và juveniles. Vibro alginolyticus có liên quan đến hội chứng zoea 2 và hội chứng nấm mysis ở giai đoạn ấu trùng, trong khi V. alginolyticus và V. harveyi có liên quan đến hội chứng Bolitas. Hội chứng Bolitas là hội chứng ở ấu trùng tôm thẻ chân trắng P. vannamei liên quan đến sự tách rời các tế bào biểu mô khỏi ruột và gan tụy, xuất hiện dưới dạng những quả cầu nhỏ trong đường tiêu hóa. Rõ ràng, các hội chứng mô bệnh học ở ruột và gan tụy của TPD do Vp-JS20200428004-2 gây ra khác với hội chứng Bolitas. Ngoài ra, các dấu hiệu lâm sàng của TPD khác với các dấu hiệu lâm sàng của hội chứng Bolitas, bao gồm giảm ăn, chậm lớn, bơi lờ đờ và giảm cơ chế trốn thoát. Như vậy, TPD được kết luận là một bệnh mới do Vibrio gây ra ở giai đoạn hậu ấu trùng của tôm thẻ chân trắng P. vannamei.
Tóm lại, dựa trên phân tích có hệ thống bao gồm phân lập, xác định và xét nghiệm tác nhân gây bệnh theo bốn tiêu chí theo nguyên tắc của Koch, chúng tôi xác định rằng chủng V. parahaemolyticus (Vp-JS20200428004-2) mới là tác nhân gây bệnh liên quan đến TPD ảnh hưởng đến ngành tôm nuôi vào năm 2020. Mầm bệnh mới có độc lực cao đối với tôm giai đoạn hậu ấu trùng và có thể gây ra những thay đổi mô bệnh học cấp tính và nghiêm trọng ở gan tụy và ruột giữa. Nguy cơ dịch bệnh và tổn thất trong giai đoạn hậu ấu trùng do mầm bệnh mới này gây ra đáng được quan tâm hơn nữa.
4. Vật liệu và phương pháp
4.1. Lấy mẫu và thử nghiệm Tôm
Hậu ấu trùng tôm P. vannamei (PL7, chiều dài cơ thể 6–8 mm) bị nhiễm bệnh được lấy mẫu từ một trang trại nuôi tôm ở Ganyu, tỉnh Giang Tô, vào ngày 28 tháng 4 năm 2020. Những con tôm trong tình trạng gần chết được cố định trong 4% paraformaldehyde để kiểm tra mô bệnh học và 2,5% dung dịch glutaraldehyde để quan sát bằng kính hiển vi điện tử truyền qua. Hậu ấu trùng tôm khỏe mạnh (PL3, chiều dài cơ thể 4–6 mm) được thu thập từ một trang trại nuôi tôm ở Duy Phường, tỉnh Sơn Đông và nuôi trong hai ngày, sau đó được sử dụng cho thử nghiệm cảm nhiễm.
4.2. Phát hiện 8 mầm bệnh tôm đã biết trong các mẫu bệnh
Sự hiện diện của 8 mầm bệnh tôm đã biết (bao gồm WSSV, IHHNV, VAHPND (mồi AP4-F/R), EHP, SHIV, YHV, TSV và IMNV) trong các mẫu bệnh đã được phát hiện bằng cách sử dụng các phương pháp được khuyến nghị trong Sổ tay xét nghiệm chẩn đoán động vật thủy sản. Ngoài ra, việc phát hiện SHIV và EHP được tiến hành theo các giao thức đã được báo cáo trước đó. Tổng số DNA được chiết xuất từ các mẫu được bảo quản trong ethanol 95% bằng Bộ DNA Động vật Biển TIANamp (Tiangen, Bắc Kinh, Trung Quốc) theo quy trình của nhà sản xuất. Tổng RNA được chiết xuất bằng cách sử dụng bộ RNA virus QIAamp (Qiagen Sciences, Gaithersburg, Maryland). Nồng độ và chất lượng của DNA/RNA chiết xuất được đánh giá bằng Máy quang phổ NanoDrop 2000c ở bước sóng 260 và 280 nm (Thermo Scientific, Waltham, MA, USA).
4.3. Phân lập vi khuẩn
Sau khi khử trùng bằng cồn 75% và rửa bằng dung dịch đệm PBS (pH 7,2; Solarbio) trong ba lần, tôm trong trạng thái gần chết từ bể nuôi được đồng nhất hóa trong 0,5 mL dung dịch đệm PBS vô trùng. Thạch Marine 2216 được sử dụng để phân lập và tinh chế vi khuẩn ở 28°C. Thạch đậu nành Trypticase bổ sung 2% NaCl (TSA+) được sử dụng để nuôi cấy vi khuẩn ở 28°C. Các vi khuẩn phân lập được bảo quản trong môi trường Marine Broth 2216 chứa 15% (v/v) glycerol ở −80°C. Quy trình phân lập cũng được áp dụng để phân lập lại các chủng chiếm ưu thế từ tôm trong thử nghiệm cảm nhiễm.
4.4. Xác định vi khuẩn
Một khuẩn lạc riêng biệt được chọn từ đĩa TSA+ và được hoàn tan trong 50 µL nước vô trùng, sau đó đun sôi ở 95°C trong 10 phút. Sau khi ly tâm ở tốc độ 3000 × g trong 30 giây, chất nổi phía trên được sử dụng làm mẫu để phát hiện PCR.
Để xác định vi khuẩn, trước tiên, chúng tôi đã áp dụng phân tích trình tự gen 16S rRNA để cung cấp phân loại cấp chi của chủng, sau đó áp dụng MLSA dựa trên ba gen mã hóa protein (rctB, rpoD và toxR) để xác định chủng theo phương pháp được mô tả bởi Pascual và cộng sự (2010). Các chuỗi liên kết của việc sắp xếp trình tự các chuỗi rpoD–rctB–toxR đã được xử lý và cấu trúc liên kết cây thu được được đánh giá bằng cách sử dụng phân tích bootstrap dựa trên thuật toán neighbor-joining với 1000 lần lặp lại được tích hợp trong phần mềm MEGA7.
Các mồi phổ biến để phát hiện 16S rDNA của vi khuẩn được sử dụng trong nghiên cứu này là 27F và 1492R (Bảng 1) theo các nghiên cứu trước đây. Hỗn hợp phản ứng PCR (25 µL) cho 16S rDNA bao gồm 12,5 µL hỗn hợp ExTaq (Takara, Đại Liên, Trung Quốc), 1 µL của mỗi mồi (10 mM) và 1 µL mẫu DNA. Các khuếch đại PCR thu được từ phản ứng sau: 95°C trong 5 phút, tiếp theo là 30 chu kỳ ở 95°C trong 30 giây, 55°C trong 30 giây và 72°C trong 1 phút 20 giây với bước cuối cùng ở 72°C trong 7 phút.
Bảng 1: Trình tự mồi của rctB, rpoD, toxR, ldh và pirABVp cho xét nghiệm PCR.

Theo các báo cáo trước đây, trình tự gen RCtB và rpoD được thu thập thông qua chương trình nhiệt: (i) 95°C trong 5 phút; (ii) 10 chu kỳ ở 95°C trong 1 phút; 54°C trong 2 phút; 72°C trong 1 phút 15 giây; (iii) 25 chu kỳ ở 95°C trong 35 giây; 54°C trong 2 phút; 72°C trong 1 phút 15 giây; (iv) kéo dài ở 72°C trong 10 phút và quá trình khuếch đại đoạn toxR được hoàn thành bằng phương pháp PCR hạ xuống: (i) 95°C trong 5 phút; (ii) 8 chu kỳ ở 95°C trong 1 phút; 62°C trong 2 phút; 72°C trong 1 phút 15 giây, giảm 1°C mỗi chu kỳ; (iii) 27 chu kỳ ở 95°C trong 35 giây; 54°C trong 2 phút; 72°C trong 1 phút 15 giây; (iv) kéo dài ở 72°C trong 7 phút.
Các thử nghiệm sinh hóa của Vp-JS20200428004-2 được tiến hành bằng API 20NE (BIOMERIEUX, Marcy I’Etoile, Pháp) sau khi ủ trong 48 giờ theo quy trình trong các báo cáo trước đó.
4.5. Phân tích các gen độc lực ở chủng phân lập
Các gen độc lực, gen haemolysin phụ thuộc lecithin (ldh) và pirAB2020Vp, ở V. parahaemolyticus đã được phát hiện theo báo cáo trước đó. Các gen mục tiêu pirAVp (284 bp) và pirAVp (392 bp) được khuếch đại theo Han và cộng sự (2015). Tất cả các mồi liên quan được liệt kê trong Bảng 1 và PCR đặc hiệu ldh được thực hiện ở 94°C trong 5 phút sau đó là 35 chu kỳ ở 94°C trong 30 giây, 52°C trong 30 giây và 72°C trong 30 giây và chu kỳ cuối cùng ở 72°C trong 7 phút. Gen mục tiêu pirAB2020Vp được khuếch đại bằng 35 chu kỳ ở 94°C trong 40 giây, 50°C trong 40 giây và 72°C trong 2 phút 10 giây sau khi biến tính trong 5 phút ở 95°C và chu kỳ cuối cùng ở 72° C trong 7 phút theo hướng dẫn của OIE.
4.6. Thử nghiệm cảm nhiễm bằng cách ngâm
Hậu ấu trùng tôm P. vannamei khỏe mạnh được nuôi tạm thời trong nước biển vô trùng (21°C) trong hai ngày và sau đó được chia ngẫu nhiên thành 5 nhóm (tức là, bốn nhóm bị cảm nhiễm và một nhóm đối chứng), 20 con/nhóm với hai lần lặp lại cho mỗi nhóm. Chiều dài cơ thể trung bình của tôm là 5,5 mm ± 0,2 mm (n = 10). Thử nghiệm cảm nhiễm được thực hiện như mô tả trước đây của Tran và cộng sự (2013) với một số điều chỉnh.
Để chuẩn bị vật liệu cấy vi khuẩn được sử dụng trong thử nghiệm cảm nhiễm, chủng Vibrio JS20200428004-2 được ủ trong môi trường Tryptic Soy Broth có thêm NaCl (TSB+) để qua đêm ở 28°C. Nồng độ của dung dịch vi khuẩn được điều chỉnh đến giá trị 1,0 của OD600 (tương ứng khoảng 109 tế bào/mL) trong máy đọc vi đĩa (Don Whitley Scientific Limited, Shipley, West Yorkshire, Anh) và sau đó được xác nhận bằng phương pháp đếm khuẩn lạc trên đĩa.
Vi khuẩn thu được được ly tâm ở tốc độ 6000 vòng/phút trong 10 phút ở 4°C, rửa sạch và hòa tan lại ba lần bằng nước biển vô trùng và cuối cùng được pha loãng thành 1,83×107–1,83×104 CFU/mL trong nước biển (đã được đun sôi trước đó) như nhóm bị nhiễm bệnh. Tôm ngâm trong 1000 mL nước biển chỉ được sử dụng làm nhóm đối chứng. Tỷ lệ chết được theo dõi 2 tiếng/lần trong 24 giờ và nồng độ gây chết trung bình (LC50) sau đó được tính toán. Tôm chết và tôm gần chết được loại bỏ, tôm gần chết được cố định trong 4% paraformaldehyde, sau đó vi khuẩn được phân lập lại và xác minh theo quy trình tương tự như phương pháp được mô tả ở trên.
4.7. Mô bệnh học
Tôm cố định với chất cố định 4% PFA–PBS từ bể nuôi và nhóm bị nhiễm bệnh trong phòng thí nghiệm được nhúng parafin ngay sau khi khử nước bằng gradient dung dịch ethanol. Một slide của mỗi mẫu được nhuộm bằng H&E theo quy trình mô học thông thường được mô tả bởi Lightner (1996). Phân tích kính hiển vi điện tử truyền qua được thực hiện theo giao thức trong báo cáo trước đó.
Theo Ying Zou, Guosi Xie, Tianchang Jia, Tingting Xu, Chong Wang, Xiaoyuan Wan, Yingxia Li, Kun Luo, Xiaodong Bian, Xiuhua Wang, Jie Kong và Qingli Zhang
Nguồn: https://www.ncbi.nlm.nih.gov/pmc/articles/PMC7558154/
Biên dịch: Huyền Thoại – Bình Minh Capital
Xem thêm:
- Nghiên Cứu Mới Xác Nhận Tác Động Tích Cực Của Dầu Krill Có Chứa Astaxanthin Lên Sự Tăng Trưởng Của Tôm Thẻ Chân Trắng Trong Điều Kiện Độ Mặn Cao
- Mô Hình Nuôi Tôm Thẻ Chân Trắng Công Nghiệp Tại Trung Quốc
- Ảnh Hưởng Của Giới Tính Đến Tập Tính Ăn Của Tôm Thẻ Chân Trắng (Litopenaeus vannamei)
English